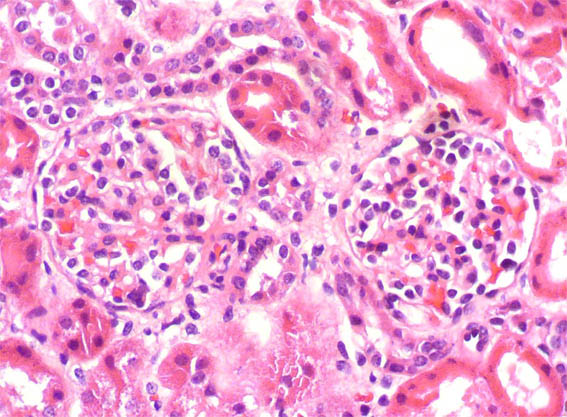

CASO
130 (Diciembre de 2016)
Datos clínicos:
Niño de 9 años de edad, desde los 2 años presenta síndrome nefrótico. No hay otros antecedentes personales y no hay historia familiar de enfermedad renal. Biopsia renal a los 2 años de edad diagnosticada como cambios glomerulares mínimos (no lesiones segmentarias; inmunofluorescencia negativa) (Figuras 1-3). Múltiples recaídas: entre 2 y 3 por año. Desde hace un año corticorresistente. Creatinina sérica hace un año: 0,6 mg/dL, ahora: 1,2 mg/dL. Se hace nueva biopsia renal.
Observe las imágenes.

Figura 1. Primera biopsia. H&E, X100.
Figura 2. Primera biopsia. H&E, X400.

Figura 3.
Primera biopsia. Tricrómico de Masson, X400.
SEGUNDA BIOPSIA:

Figura 4. H&E, X100.

Figura 5. H&E, X200.

Figura 6. H&E, X400.

Figura 7. PAS, X200.

Figura 8. PAS, X400.

Figura 9. Plata-metenamina, X400.

Figura 10. Plata-metenamina, X400.

Figura 11. Microscopía electrónica, X8.000.
Inmunofluorescencia directa para IgA, IgG, IgM, C3 y C1q: Negativas.
¿Cuál es su diagnóstico?
¿Es la misma enfermedad desde la primera biopsia o hubo una "transformación" de la enfermedad?
Ver
diagnóstico y discusión
[Arriba]
|